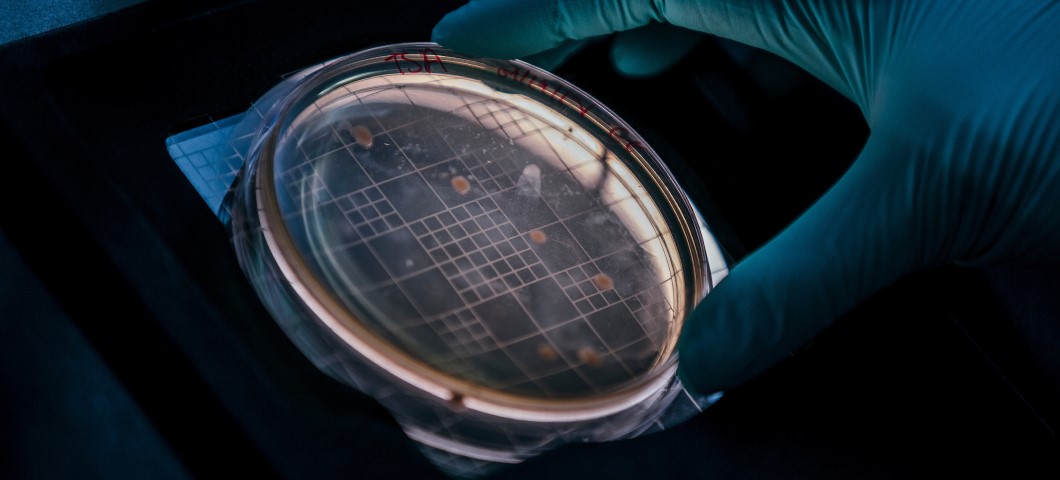

Biosafety Program
The mission of the Biosafety Program at MSU is to ensure a safe environment for individuals working with biohazardous materials and to ensure the protection of the community and environment by preventing exposure to biohazardous materials. To accomplish this, the Biosafety Program provides technical advice to Principal Investigators on laboratory containment, security, and safety procedures.
|
|
For Biosafety questions or concerns, please contact one of the following:Amy RobisonBiosafety Officer (406) 994-6733 Jovanka VoyichIBC Chair (406) 994-7199
|
|
